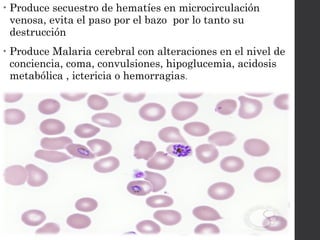
• Produce secuestro de hematíes en microcirculación
venosa, evita el paso por el bazo por lo tanto su
destrucción
• Produce Malaria cerebral con alteraciones en el nivel de
conciencia, coma, convulsiones, hipoglucemia, acidosis
metabólica , ictericia o hemorragias.

El documento aborda las generalidades del Plasmodium, causante de la malaria, incluyendo su transmisión, morfología, ciclo evolutivo y los diferentes tipos de Plasmodium como P. falciparum, P. vivax, P. malariae y P. ovale, junto con sus características clínicas y epidemiológicas. Se discuten los mecanismos de transmisión, especialmente a través del mosquito Anopheles, así como el diagnóstico y tratamiento de la enfermedad. Además, se examinan aspectos relacionados con la inmunidad y la resistencia a medicamentos.